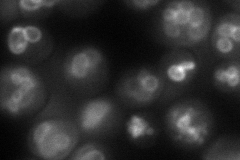
YKL064W
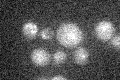
YKL064W

View description
Vacuolar membrane protein required for magnesium homeostasis; putative magnesium transporter; has similarity to Alr1p and Alr2p, which mediate influx of Mg2+ and other divalent cations
Localization:
Intensity:
Fold change:
Significance:
-
C’ GFP library in SD

below threshold17.48 -
N' NOP1pr-GFP in SD
vacuole membrane96.8624 -
N' TEF2pr-mCherry in SD

below thresholdN/A -
N' NATIVEpr-GFP in SD

missing0 -
N' TEF2pr-VC and Cyto-VN in SD

vacuole membrane40.0315 -
C’ GFP library in SD+DTT

cytosolN/AN/ANo -
C’ GFP library in SD+H2O2

cytosolN/AN/ANo -
C’ GFP library in Starvation Media
cytosolN/AN/AYes -
C’ GFP library on the background of Pup2-DaMP

below threshold -
C’ GFP library on the background of CCT mutant

below thresholdN/AN/ANo
